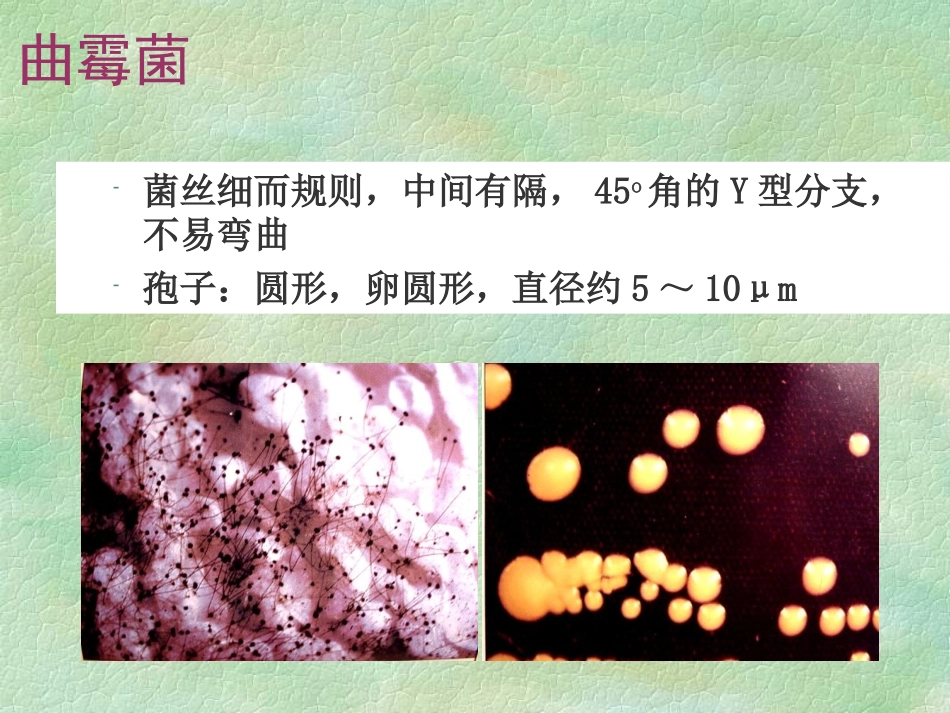
变应性支气管肺曲霉病课件_第2页

变应性支气管肺曲霉菌病allergicbronchopulmonaryaspergillosis(ABPA)陈云霞2016
07曲霉菌菌丝细而规则,中间有隔,45o角的Y型分支,不易弯曲孢子:圆形,卵圆形,直径约5~10μmABPA1952年在英格兰发现是一种免疫介导的肺部疾病,由于对曲霉菌抗原过敏引起,烟曲霉菌最常见具有潜在破坏性的肺疾病尽管此疾病主要发生在哮喘病人,但哮喘病人只有少数会发生ABPA尽管有一定的家族倾向,家族性的ABPA极少见ABPA由于没有统一的诊断标准和标准化的试验,所以没有确切的ABPA的发病率在哮喘中发病率约1-2%至39%(入住ICU的重症哮喘)这些的哮喘情况多较严重,病程长,发病年龄早,有鼻炎史,但也可以发生在轻度哮喘ABPA也可发生在没有哮喘的病人中ABPA其他类型的真菌偶尔也可引起同样的临床症状,称为变应性支气管肺霉菌病(allergicbronchopulmonarymycosesABPM)ABPM中ABPA最常见,其他包括白色念珠菌(candidaalbicans)、长孺孢霉(helminthosporiumspp
)、月状弯孢菌(curvularialunata)、夏威夷德氏霉(drechslerahawaiiensis)、葡柄霉(stemphyliumlanguinosum)、酿酒酵母菌(saccharomycescerevisiae)、假菌样真菌(pseudallescheriaboydii)也产生同样临床症候群,因此称之为变应性支气管肺真菌病
即有念珠菌属、青霉菌属、弯孢菌属和Dreschleria
定义ABPA变应性支气管肺曲霉病是人体对寄生于支气管内的曲霉抗原发生变态反应所引起的一种肺部疾病
其特征为对存在于支气管分支的烟曲霉抗原呈现免疫应答,并引起肺浸润和近端支气管扩张
流行病学最常见